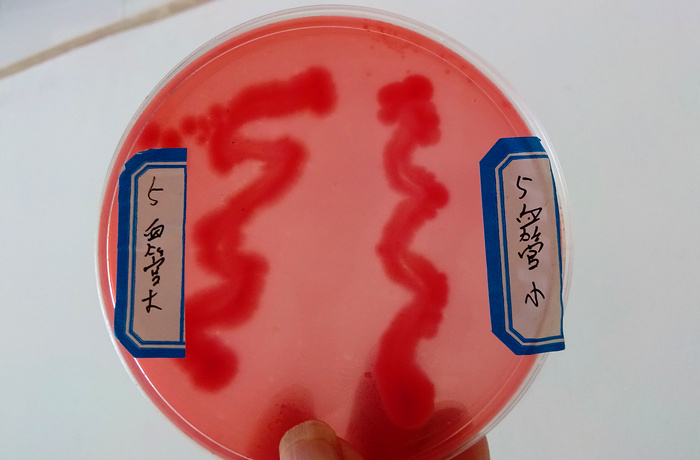
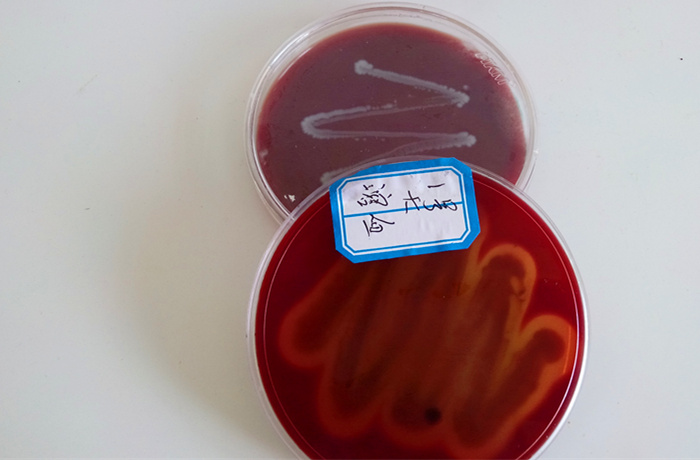

眼鏡蛇蛻皮不暢,眼睛發(fā)藍動物疫病診斷報告書

|
永州職業(yè)技術學院生物科技系動物疫病診斷報告書 |
||||||||
|
送檢單位 |
永州異蛇科技有限公司 |
聯(lián)系電話 |
|
|||||
|
種 類 |
蛇 |
日 齡 |
|
品 種 |
眼鏡蛇 |
發(fā)病時間 |
2017、6 |
|
|
發(fā)病情況 |
存欄數(shù) |
|
發(fā)病數(shù) |
17 |
死亡數(shù) |
|
||
|
眼鏡蛇蛻皮不暢,眼睛發(fā)藍、模糊不透明,皮下有積液積膿,惡臭,病蛇精神差,有腹瀉現(xiàn)象 |
||||||||
|
臨床癥狀 |
皮下化膿,惡臭,腹瀉。精神萎靡 |
|||||||
|
剖檢變化 |
表皮易剝離,皮下化膿,惡臭,腹部皮膚有出血點。胃內較空虛,肝包膜下有小膿包,脂肪上有大量出血點,腎臟上有化膿灶 |
|||||||
|
實驗室診斷 |
細菌分離培養(yǎng):革蘭氏陰性小桿菌
|
|||||||
|
診斷結論 及建議 |
大腸桿菌感染引致敗血癥
|
|||||||
|
|
|
|
|
2014年 6 月25 日 |
||||